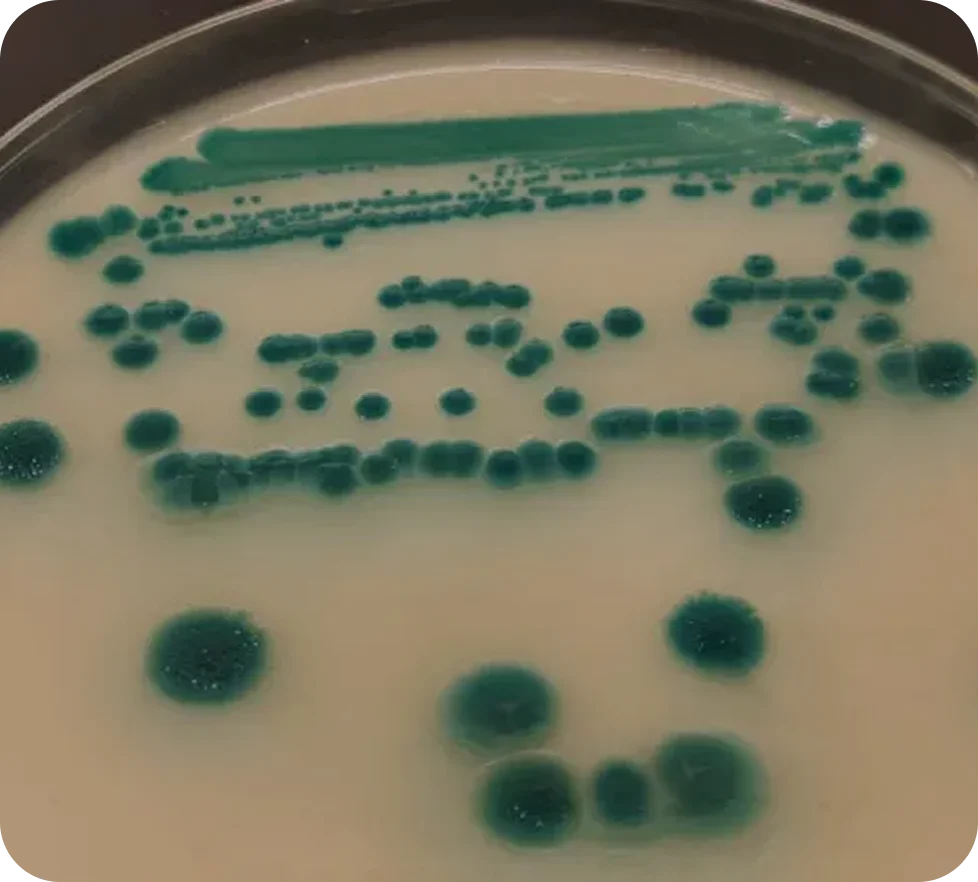

>> MÉTODO MICROKIT
TECNOLOGÍAS ÚNICAS Y PATENTADAS
La eficacia, exactitud y robustez que otros dan por supuesto que funcionan con sus métodos (pero se equivocan), nosotros la garantizamos con el nuestro


>> FASE 1
Exploración del Desafío
Te escuchamos:
- ¿Qué microorganismos estás buscando?
- ¿Cuáles sabes que no siempre aciertas en tus informes?
- ¿Qué proporción de errores graves (falsos negativos) cometes en los servicios intercomparativos?
- ¿Qué proporción de falsos positivos? ¿Y desviaciones cuyo valor de recuento absoluto están por debajo del 90% de la media consensuada?
Y para posicionarnos entre todos ellos
- ¿Qué proporción de estos mismos 3 tipos de errores comete la media de los demás laboratorios?

Aplicamos el conocimiento recogido en más de 200 rondas intercomparativas, (26 años), con cientos de laboratorios como el tuyo implicados, para identificar los errores más comunes que afectan la fiabilidad de tus resultados analíticos. Nadie más hace esto: o diseñan medios y kits, o coordinan servicios intercomparativos, o analizan muestras. Nosotros combinamos el conocimiento que hemos adquirido mediante estas tres herramientas, para crear un estado alterado de conciencia que nos permite encontrar las soluciones a los errores.
Porque subimos el árbol que nos tapaba el bosque, ampliamos nuestra visión de éste desde arriba, y además nos lanzamos a otear todas las soluciones mediante un efectivo vuelo de águila.

>> FASE 2
Selección de Soluciones Exclusivas
Accedes a un catálogo único
Con cerca de 200 productos innovadores, desarrollados en nuestros propios laboratorios, y no disponibles en ningún otro proveedor. Como coordinadores de intercomparación, diseñadores de medios de cultivo y analistas de muestras ajenas, hemos despiezado paso a paso los protocolos oficiales de análisis, hemos encontrado los puntos críticos y los tenemos resueltos. Te ofrecemos las soluciones de cada uno de ellos. Incluso esos protocolos mejorados.
Una vez conocemos los puntos críticos de cada procedimiento analítico, estamos en condiciones de resolverlos uno tras otro.
Diseñamos productos y métodos que han sido desarrollados y perfeccionados tras décadas de observación, implantación y validación en cientos de laboratorios de microbiología de alimentos, aguas y cosméticos.


>> FASE 3
Implementación Guiada por Asesores Científicos Expertos
Implementamos contigo
La mejor combinación de tecnologías, con soporte especializado, que te guía para maximizar los tres parámetros que miden la calidad de tus análisis:
- Sensibilidad: minimiza los falsos negativos en tus análisis.
- Especificidad: acaba con los falsos positivos de tus análisis.
- Exactitud en tus resultados: obtén los recuentos más cercanos a la realidad.
No estás solo:
Recibes acompañamiento técnico continuo para aplicar las soluciones más ajustadas a tus desafíos específicos, sin necesidad del ensayo y error que ya sufrimos nosotros hace años, y con la garantía de la mejora continua en tus resultados analíticos hasta conseguir la excelencia.


>> FASE 4
Excelencia Medible
Mejora tangible en tus resultados: obtendrás un rendimiento superior en tus ensayos microbiológicos, con productos diseñados para que no te falte ninguna pieza del puzzle científico.
Aquí tienes los datos que, tras más de 200 rondas intercomparativas (25 años), demuestran los mejores resultados analíticos de quienes aplican nuestras metodologías:
https://www.medioscultivo.com/mejora-tus-resultados-analiticos-gracias-a-nuestra-innovacion/
Sube de la calificación habitual de 7 sobre 10, a un 9,5: resultados más sensibles, más específicos y más exactos-precisos, en definitiva más fiables, con muy poca incertidumbre (máxima certeza) y avalados por el método científico y la experiencia real.